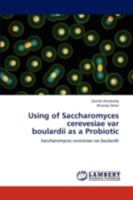
Using of Saccharomyces Cerevesiae Var Boulardii As a Probiotic 3843393028 Book Cover

Most Popular Books
Using of Saccharomyces Cerevesiae Var Boulardii As a Probiotic
Out of Stock

Biosynthesis of Ag and ZnO nanoparticles using plants extracts: Biosynthesis of Ag and ZnO nanoparticles using plants extracts and study their antimicrobial properties
Out of Stock

The Antibacterial Activity of Lab Against Listeria Monocytogenes
Out of Stock